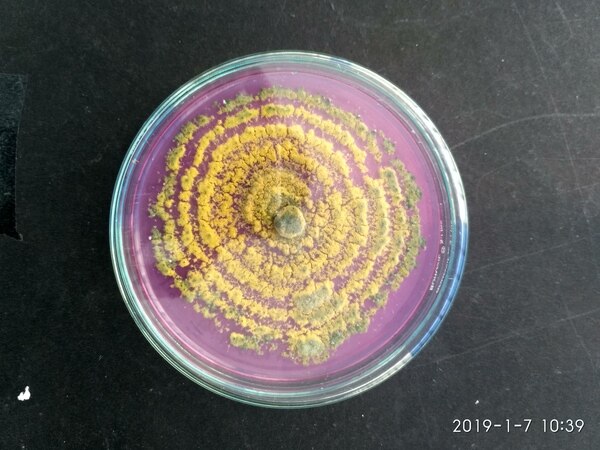
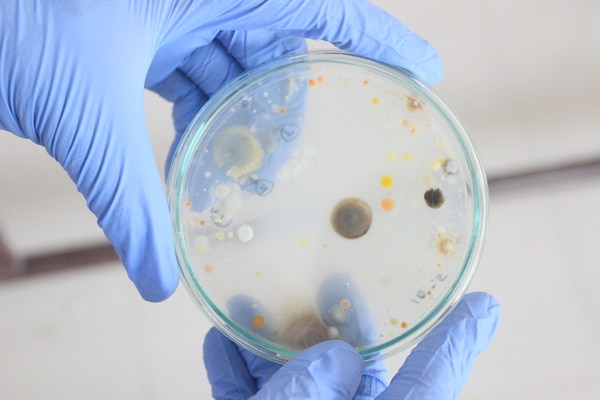

INR 2500

INR 10000

INR 1500

INR 25000

INR 1000

INR 2500

INR 450
INR 1500

INR 258
Ayush Approved |Higene + 100ml |Sanitizer |Gel Base |Top-up pack |Gel base sanitizer |Analytical services |Herbal extract testing |Ayush product testing |natural product extraction |Toxicity |Cytotoxicity Testing |Cell culture |cell line testing |Biocompatibility evaluation |SEM analysis |Morphological analysis |TEM analysis |Crystalography |Research proposal writing |Research article editing |Writing for Government |Microbial technique |Upstream and downstream processing |Analytical Techniques |Molecular Biotechnology |Animal cell culture |Dental Statistics |BioStatistics |ANOVA |correlation |Gene identification |Gene detection |Microbiology |Life science